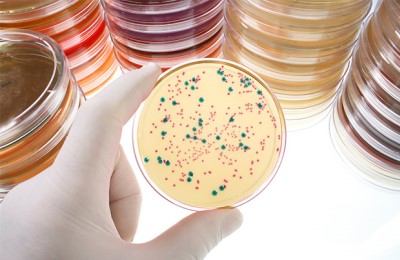

Ларингит у детей – острое воспаление гортани, частой причиной заболевания есть вирусная инфекция верхних дыхательных путей.
Своевременная диагностика заболевания поможет вовремя помочь ребенку, ведь ларингит часто сопровождается стенозом гортани, вследствие чего, ребенок может быстро задохнуться. Лечение ларингита у детей занимает особое место среди педиатрических заболеваний, ведь оно опасно осложнениями.
Как заподозрить начало заболевания у ребенка?
Ларингит у грудничка можно заподозрить, когда малыш проявляет беспокойство, вялый, капризный, есть слизистые выделения из носа, сильный кашель, если малыш кричит слышаться хрипы.
В тяжелых случаях может посинеть носогубный треугольник.
Ларингит у детей до года сопровождается высокой гипертермией, беспокойством ребенка, высокочастотным кашлем, наличием слизистых выделений из носа, хриплым плачем.
Согласно этому, ларингит у грудничка и ларингит у детей до года имеет различное течение.
Единственное, что их объединяет – это риск развития стеноза подъязычного простора.
Врачи отмечают, что ларингит у детей часто проявляется острыми респираторными инфекциями и может сопровождаться кашлем, охриплостью и затруднением дыхания. Клиническое течение болезни варьируется от легкой формы до тяжелых случаев, требующих госпитализации. Специалисты подчеркивают важность ранней диагностики и адекватного лечения, чтобы избежать осложнений. В большинстве случаев лечение включает ингаляции, противовоспалительные препараты и, при необходимости, кортикостероиды. Врачи также рекомендуют обеспечить ребенку покой и обильное питье, что способствует быстрому восстановлению. Профилактика, включая закаливание и избегание контакта с инфекционными больными, играет ключевую роль в снижении заболеваемости.

Причины и клинические проявления
Причины заболевания разнообразные, в зависимости от состояния иммунной системы, организм человека может поражаться вирусами, бактериями, быть чувствительным к перепадам воздуха.
Детский ларингит имеет несколько причин:
вирусный этиологический фактор – аденовирусы, вирус гриппа, кори;
- аллергенный – краски, лаки, бытовая техника, пыль, шерсть животного;
- переохлаждение;
-
анатомо-физиологическое строение ребенка – узкая носоглотка и гортань.
Когда возникает воспаление, сужается гортань за счет отека тканей, что утрудняет поступление воздуха;
- механический этиологический фактор – длительный крик, громкий разговор;
- состояние воздуха – сухой и горячий воздух, вдыхание выхлопных газов, нахождение ребенка в прокуренном помещении;
- попадание инородного тела;
- гастроэзофагальный рефлюкс – раздражение слизистой гортани содержимым желудка.
Симптомы болезни начинаются остро, ребенок часто обеспокоен, отказывается от приема пищи, вследствие болезненного глотания, непрерывного кашля.
Клинические симптомы заболевания:
- учащенное и затрудненное дыхание;
- лающий кашель, интенсивность которого увеличивается утром;
- приступы удушья (вследствие стеноза);
насморк;
- гиперемия слизистой горла, отечность стенок;
- охриплость голоса, афония;
- сухость во рту, чувство першения;
- гипертермия;
- головная боль;
- общее недомогание.
Течение ларингита составляет три недели.
Но, в каждом случае все индивидуально. Выявив причины, и клинические симптомы, можно оказывать помощь.
Чем можно помочь до того, как обследует врач?
Распознав признаки острого ларингита, и вызвав врача, необходимо чем-то помочь малышу.
Для этого необходимо дать пить теплую щелочную жидкость (например, «Боржоми»), можно делать теплую ножную ванну, после чего укутать ребенка и дать попить.
Из препаратов можно дать антигистаминное средство (тавегил, супрастин), чтобы снять спазм можно ввести папаверин, но при этом важно тщательно рассчитать дозировку.
Первая помощь со стороны родителей должна быть направлена на снижение отека гортани.
Если в домашних условиях невозможно качественно стабилизировать состояние ребенка, то важно лечить его в больнице.
Ларингит у детей — это воспаление гортани, которое может проявляться в виде охриплости, кашля и затрудненного дыхания. Родители часто отмечают, что заболевание может возникать на фоне простуды или вирусной инфекции. Клиническое течение ларингита может варьироваться от легкой формы с минимальными симптомами до тяжелых случаев, требующих медицинского вмешательства. Важно помнить, что у маленьких детей риск развития стенозирующего ларингита, который может привести к затруднению дыхания, значительно выше.
Методы лечения включают обильное питье, ингаляции с физраствором и использование противовоспалительных средств. В некоторых случаях врачи могут рекомендовать кортикостероиды для уменьшения отека. Также важно создать комфортные условия: увлажнять воздух и избегать раздражителей, таких как дым или холодный воздух. Родители должны внимательно следить за состоянием ребенка и при ухудшении симптомов обращаться за медицинской помощью.
Что нельзя?
Если ребенок заболел, не рекомендуется давать компоты, морсы в качестве обильного питья. Также, оградить его от сквозняков, не позволять играть с другими детьми, ведь он заразен.
Важно! Нужно соблюдать постельный режим, парить ноги, важно следить, чтобы ребенок принимал все лекарства, которые назначил врач. Если начался приступ, позволить ребенку занять удобную позицию для дыхания, немедленно вызвать скорую помощь, которая сможет снять угрожающее для жизни состояние.
Не рекомендовано ждать, пока приступ закончится. Если состояние маленького пациента ухудшается, немедленно госпитализировать его в больницу, где его будут лечить опытные специалисты.
Диагностика заболевания
Первым делом, врач должен собрать жалобы пациента, провести общий осмотр, собрать анамнез заболевания.
Также диагностика заболевания должна включать сдачу общего анализа крови, мазка с поверхности небных дуг и задней стенки глотки.
Необходимо сдать анализ на выделение культуры возбудителя с мазка для специфической диагностики инфекции.
Сколько делать анализов, определит врач, ведь он отталкивается от результатов, чтобы правильно лечить.
Важно! Нужно делать ларингоскопию – осмотр гортани с помощью специального гортанного зеркала или же эндоскопа. С помощью исследований, можно определить, заразен пациент для окружающих или нет.
Терапия в домашних условиях
Лечение ларингита у детей подразумевает комплекс мероприятий, которые в определенные сроки смогут вылечить малыша:
постельный режим, полноценное питание;
- обильное питье (чаи, фруктовые соки), при необходимости – дезинтоксикационная терапия реосорбилактом;
- прием витамина С, рутина;
- антигистаминные средники;
- бронхо-секретолитические средства (амброксол, ацетилцистеин);
- противовирусные средства (ремантадин, арбидол, амизон, мефенаминовая кислота);
- антипиретики – парацетамол, ибупрофен.
Соблюдение этих пунктов окажет помощь пациенту на начальном этапе и до конца заболевания.
Ларингит у детей требует внимание со стороны родителей и врачей, ведь если принять неверные меры, может начаться приступ ларингоспазма.
Когда необходима срочная госпитализация?
К показаниям к срочной госпитализации, относят:
- частота дыхания более 30/мин;
- частота сердечных сокращений более 130/мин;
- систолическое артериальное давление менее 90 мм.рт.мт., диастолическое – менее 60 мм.рт.мт.;
- сатурация кислорода менее 92 процента, наличие центрального цианоза (посинение конечностей, тела);
- смена сознания;
- наличие дыхательной недостаточности, асфиксия;
- гипертермия более 39 градусов по Цельсию.
Госпитализация в больницу необходима при угрожающем состоянии для ребенка.
Чаще всего госпитализация происходит, когда лечащий врач не может гарантировать качественного лечения в амбулаторных условиях.
Также при необходимости круглосуточного наблюдения за малышом, неотложного лечения. Лечение в больнице при ларингите у детей проходит так.
Необходимо для постоянного контроля за состоянием, в случае изменения течения болезни, примутся меры в последующей терапевтической тактике. Приступ ложного крупа лечат в зависимости от его стадии.
Приступ в катаральной стадии можно лечить, применяя сухое тепло на шею, ингаляции противоотечной смесью, паровые ингаляции. Назначают аскорутин и антигистаминное средство.
Приступ в стенотической стадии нужно лечить с помощью искусственной вентиляции легких, проводится седация для уменьшения инспираторных усилий. Применяют глюкокортикоиды, антигистаминные средства, бронхолитики, муколитики.
Приступ в асфиктической стадии лечат с помощью интубации трахеи, применения искусственной вентиляции легких, ингаляция адреналина с применением выше перечисленных препаратов.
Профилактические методы
Профилактика ларингита у детей включает: полноценное питание, проветривание помещения каждые 3 часа.
Необходимо мыть руки с мылом после посещения общественных мест, избегать мест скопления людей, не заниматься самолечением, а вовремя обращаться к врачу, придерживаться рекомендаций доктора.
Чтобы ребенок не болел острыми респираторными инфекциями, которые проявляются ларингитом, бронхитом, трахеитом. Важно делать профилактические прививки от гриппа.
Кроме того, чтобы иммунная система малыша была защищенной и не позволяла проникать вирусам внутрь, необходимо принимать препарат Immuity. Помощь оказывается благодаря 18 целебным травам и 6 витаминам.
При использовании препарата, иммунная система быстро (в течение двух дней) начинает уничтожать патогенные микроорганизмы, что препятствует возникновению осложнений.
Известно, что в первые дни простуды человек заразен, родители малыша также могут принимать Immuity для профилактики.
Сам препарат не нарушает биохимических реакций в организме, а повышают активность иммунных клеток. Сколько делать профилактику или лечение этим препаратом, определит врач.
Осложнения
Ларингит у детей может осложниться развитием ложного крупа (стеноза подъязычного простора), который проходит катаральную, стенотическую и асфиктическую стадии. Клинические проявления возникают внезапно, в ночное время.
Родителям нужно быть особо внимательными к состоянию малыша.
Симптомы катаральной стадии ложного крупа характеризуются охриплостью голоса, лающим кашлем, утрудненным дыханием.
Симптомы стенотической стадии дополнительно характеризуются одышкой, грубым дыханием, цианозом, вовлечением податливых участков грудной клетки, повышенной потливостью.
Симптомы асфиктической стадии характеризуются тотальным цианозом, нитевидным пульсом, снижением артериального давления, расширением зрачком, потерей сознания. Сколько может длиться приступ, зависит от реактивности бронхиальной системы.
Снять его можно с помощью введения глюкокортикоидов, если это неэффективно, тогда переходят к искусственной вентиляции легких.
Первая помощь должна оказываться мгновенно, все манипуляции необходимо делать быстро, но для этого понадобятся квалифицированные медики.
Также к осложнениям относят: гнойной ларингит у ребенка, флегмона шеи, если заболевания не было вовремя диагностировано, медиастинит, сепсис и абсцесс легкого. Вылечить ребенка в таком случае будет сложнее, понадобится больше время пребывания в стационаре.
Ларингит может проявляться при бронхите, пневмонии, гриппе, коклюше, коре и даже при дифтерии. Кроме того, есть и другие причины ларингита: перенапряжение голоса, аллергические реакции.
Характерные признаки заболевания: смена голоса, охриплость, афония (отсутствие звуков), постоянное желание почистить горло. При тяжелом течении возникают гипертермия, общее недомогание, боль в горле, нарушение глотания, что может привести к одышке.
При ларингоскопии определяется гиперемия и отек слизистой оболочки гортани. Если есть белые пленки в горле, необходимо исключить дифтерию.
Пациент Олег, 10 лет. Мальчик был госпитализирован с диагнозом острый ларингит. Симптоматика заболевания включала: охриплость, постоянное желание почистить горло, лающий кашель, боль в горле, повышение температуры.
При ларингоскопии определяется гиперемия слизистой оболочки гортани. После проведения обследования и подтверждения первичного диагноза назначено лечение: прием антибиотиков, бронхолитиков, антипиретиков, антигистаминные средства и местные анестетики, для повышения иммунитета – Immunity.
Короткая справка. Препарат Immunity является эффективным средством для стимуляции иммунных клеток, которые быстро борются с микроорганизмами и сопутствуют скорейшему выздоровлению. Прежде чем использовать этот препарат, необходимо проконсультироваться с врачом.
Вопрос-ответ
Каковы основные симптомы ларингита у детей?
Основные симптомы ларингита у детей включают охриплость или потерю голоса, сухой кашель, затрудненное дыхание и боль в горле. У некоторых детей могут наблюдаться также повышенная температура и общее недомогание.
Какие методы лечения ларингита рекомендуются для детей?
Лечение ларингита у детей обычно включает покой голосовых связок, обильное питье, ингаляции с физиологическим раствором или паром, а также использование противовоспалительных и жаропонижающих средств. В некоторых случаях может потребоваться назначение антибиотиков, если есть подозрение на бактериальную инфекцию.
Когда следует обратиться к врачу при ларингите у ребенка?
Обратиться к врачу следует, если у ребенка наблюдаются признаки затрудненного дыхания, сильная охриплость, которая длится более двух недель, высокая температура, не поддающаяся лечению, или если состояние ребенка ухудшается. В таких случаях может потребоваться более серьезное медицинское вмешательство.
Советы
СОВЕТ №1
Обратите внимание на симптомы. При первых признаках ларингита, таких как охриплость, кашель или затрудненное дыхание, важно обратиться к врачу. Раннее выявление заболевания поможет избежать осложнений и ускорить процесс выздоровления.
СОВЕТ №2
Создайте комфортные условия для ребенка. Убедитесь, что в помещении, где находится ребенок, поддерживается оптимальная температура и влажность. Используйте увлажнители воздуха, чтобы предотвратить пересыхание слизистых оболочек горла.
СОВЕТ №3
Следите за режимом питья. Обеспечьте достаточное количество жидкости для вашего ребенка. Теплые напитки, такие как травяные чаи или компоты, помогут смягчить горло и уменьшить воспаление.
СОВЕТ №4
Избегайте раздражителей. Ограничьте контакт ребенка с табачным дымом, пылью и другими аллергенами, которые могут усугубить симптомы ларингита. Чистота в доме и свежий воздух помогут улучшить состояние ребенка.


вирусный этиологический фактор – аденовирусы, вирус гриппа, кори;
насморк;
постельный режим, полноценное питание;


